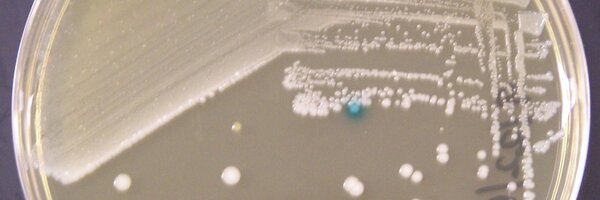
BSauders Profile Banner

Brian Sauders, PhD 🛒🔬🦠🧫🧬☣️😷
@BSauders
Followers
962
Following
22K
Media
1K
Statuses
18K
Microbiologist with a passion for food safety & scientifically sound public health policy. Find me on LinkedIn-all views my own. Cheers! #ScienceMatters
Albany, NY
Joined September 2011
There is power in truth...can we please get some truth in power?
2
9
24
🚨 Fan Love 🚨 RT for a chance to win my 2 TICKETS to the Raiders game this Sunday & an exclusive Philly Special Christmas plushies set! 🎄🏈🎟 Appreciate y'all for your support - you truly are the best. 🙌 #ProBowlVote @lanejohnson65 @jordan_mailata
292
4K
3K
SEEN: 5th Annual Fall Fundraiser for Sidewalk Warriors Troy https://t.co/G2VCi8DzGK via @TimesUnion
timesunion.com
The organization provides meals and basic necessities to the homeless and others every Thursday at 6 p.m. at the corner of 5th Avenue and State Street in Troy.
0
0
0
🚨 Weather Update: Moderate-to-heavy rain will affect most of the state through tonight. The heaviest rain will occur in the Mid-Hudson, NYC & Long Island regions between 3-9PM. Downstate could get 3-5" of rain, with isolated totals over 5". Flooding is very likely. Prepare now.
1
4
7
The first five days after the weekend are always the hardest…
101
916
10K
Truth Social has crashed from the traffic surge and in so doing accidentally created a hauntingly poignant image.
676
26K
242K
DEAN: What's the tariff on bananas? LUTNICK: Generally 10% DEAN: Walmart has already increased the cost of bananas by 8% LUTNICK: If you build in America, there is no tariff DEAN: We cannot build bananas in America
5K
28K
337K
Varsity in a nail biter at home - Anna Peles drives in the game winning run! Eagles 10-9 over a solid Ballston Spa team! 🦅🥎 #BCSD
#BCSDAthletics
1
4
7
A new analysis raises concerns over the stoppage of funding for this long-standing program, which could have major impacts on global public health for years to come. #HIV #IDtwitter #medtwitter
https://t.co/0ANMjk1Bdo
contagionlive.com
A new analysis raises concerns over the stoppage of funding for this long-standing program, which could have major impacts on global public health for years to come.
0
1
1
Raw pet food alert! 🚨Feeding cats this raw food may expose them to serious illness with HPAI. While wild felines and canines eat raw meat, domesticated animals can be exposed to many pathogens by raw food that can make both them and their owners sick. https://t.co/vy6OHlgt7G
fda.gov
This recall has been completed and FDA has terminated this recall.
0
0
0
OMG. Please read every last word of this shocker, including the emojis. Amateur hour? Is the president, is America, being properly served? Dangerous. https://t.co/9x0IWdLlit
theatlantic.com
U.S. national-security leaders included me in a group chat about upcoming military strikes in Yemen. I didn’t think it could be real. Then the bombs started falling.
859
4K
20K
JUST IN: Air traffic control audio released following a plane crash in Lancaster County, Pennsylvania. The plane, with five people on board, crashed in the parking lot of a retirement community. Multiple vehicles in the lot caught on fire. According to new audio, the pilot was
356
1K
6K